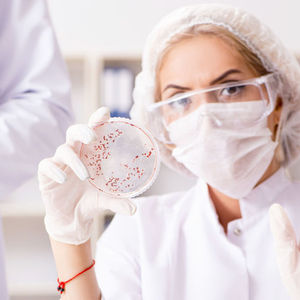

泰国公共卫生部17日表示,已发现第二例2019-nCoV,即新型冠状病毒确诊病例。这也是在中国境外发现的第三例确诊病例。
患者是一名74岁中国籍女子。13日,她从武汉乘飞机前往泰国首都曼谷,在曼谷机场被检测出发烧等疑似肺炎症状,当即被隔离,随后确诊感染新型冠状病毒。泰国公共卫生部发言人朗古(Rungrueng Kitphati)表示,目前该患者情况稳定。
在此之前,还有一名61岁中国女性旅客在泰国确诊感染新型冠状病毒。两名确诊患者目前正在负气压隔离病房中接受治疗,两人之间发病并无相关性。
泰国公共卫生部部长阿努廷(Anutin Charnvirakul)表示,目前情况仍在控制之中,泰国没有疫情爆发的迹象,并敦促当地民众保持冷静。阿努廷透露,两名患者目前状况良好,只需要再完成一些治疗程序就可以回国。公共卫生部疾病防控中心高级官员素察(Suthat Chottanapund)称,需要等到最终化验结果显示患者已经完全不携带新型冠状病毒,才能让她出院。
春节将至,前往泰国旅游的中国游客大幅增加。泰国公共卫生部已在四座有每日往返武汉的航班的机场、以及其他接受从武汉包机入境的机场加强筛查,同时要求泰国亚洲航空和中国南方航空阻止出现高烧或呼吸道感染症状的旅客登机。
除了泰国,日本也在14日确诊了一例新型冠状病毒病例,是一名曾经前往武汉的30岁中国籍男子。

世界卫生组织(WHO)此前发声明称,考虑到全球范围内人员流动频繁,在其他国家发现病例并不意外,呼吁所有国家继续为防控这一病毒做好准备。中国已经共享了从现有肺炎病例中检测到的新型冠状病毒基因基因组测序结果,使得更多国家能够快速诊断患者。
WHO表示,这种新型病毒或有人际传播风险,但仅限于家庭成员之间有限的人传人,还没有出现持续的人际传播,已向全球医院发出警告。根据当前情况,世卫组织仍不建议实施任何旅行或贸易限制措施。
去年12月底以来,武汉确诊多例由这种新型冠状病毒引起的肺炎病例。根据武汉市卫健委16日23时55分发布的通告,2020年1月15日0—24时,武汉市无新增新型冠状病毒感染的肺炎病例,治愈出院5例,新增死亡病例1例。
截至目前,武汉市累计报告新型冠状病毒感染的肺炎病例41例,已治愈出院12例,在治重症5例,死亡2例,其余患者病情稳定,患者均在武汉市定点医疗机构接受隔离治疗。累计追踪密切接触者763人,已解除医学观察644人,尚在接受医学观察119人,密切接触者中,没有发现相关病例。
香港大学“新发传染性疾病国家重点实验室”主任管轶在接受媒体采访时表示,自3日后内地无新增传染病例,而冠状病毒最长潜伏期是15天,如果接下来几天不再出现新感染病例,可以判断此次疫情已经得到控制。